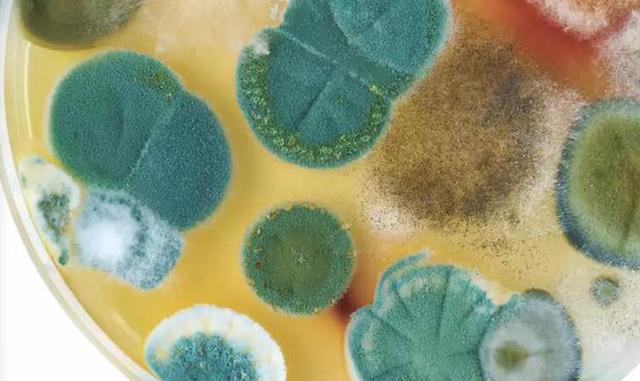

青霉素发明于1928年。
1928年英国细菌学家弗莱明首先发现了世界上第一种抗生素—青霉素,亚历山大·弗莱明由于一次幸运的过失而发现了青霉素。
导读:回眸,人类最伟大的发明——青霉素的曲折发现历史
1928年9月3日,英国著名细菌学家、医学家弗莱明发现青霉素,为使用抗生素治疗传染病开辟了道路,也标志着人类进入了合成新药的新时代。
青霉素是怎么产生的?青霉素的诞生又有什么意义?
一个偶然的发现
1928年夏,英伦三岛的天气特别闷热——伦敦大学圣玛丽医学院赖特研究中心也破例放了暑假。细菌学教授亚历山大·弗莱明(1881~1955)连实验台上杂乱无章的器皿都没有收拾好,就准备到海滨去度假了——这是他多年科研生涯中的第一次。9月初,天气渐凉,度假的人们陆续回来了。弗莱明跨进他离开多日的实验室。“糟了,长霉菌了!”弗莱明小心翼翼地取出一个个培养细菌的器皿,取到第五个时,突然惊奇地叫了起来。

实验中的弗莱明
此前,弗莱明曾从病人的脓中提取了葡萄球菌,放在盛有果子冻的玻璃器皿中培养,繁殖起来的金黄色葡萄球菌他称为“金妖精”,密密麻麻地出现在果子冻上。这“金妖精”使人生疖、长痈、患骨髓炎,引起食物中毒,很难对付。他培养它,就是为了找到能杀死它的方法。现在,他看到玻璃器皿里有一个地方沾上绿色的霉,开始向器皿四周蔓延,所以惊叫起来。
培养液受到污染而发霉,就不能再用来做实验了。通常的做法,就是把它一倒了之。但弗莱明却没有这样做,他要看是哪种霉菌在捣乱。于是拿起培养皿来仔细观察,想了解为什么发霉的培养液就不能再用了。对着亮光,他发现了一个奇特的现象:在青绿色的霉花周围出现一圈空白——原来生长旺盛的“金妖精”不见了!
弗莱明立即意识到,可能出现了某种了不起的东西。他兴奋地迅速从培养器皿中刮出—点霉菌,小心翼翼地放在显微镜下观察。透过厚厚的镜片,他终于发现这种能杀死“金妖精”的青绿色霉菌是青霉菌。随后,他把青霉菌分离出来。他还发现,“金妖精”每次要和青霉菌“短兵相接”之前,都会“望而却步”——在青霉菌前2.5厘米处“安营扎寨”。
弗莱明继续在培养液中繁殖了许多青霉菌,然后把过滤过的培养液滴到“金妖精”中去。奇迹出现了——几小时之内“金妖精”们全部死亡。他又把培养液稀释1/2、1/4……直到1/800,分别滴到“金妖精”中。结果,他发现“金妖精”们全部“死光光”。他还发现,青绿色霉花还能杀灭白喉菌、炭疽菌、链球菌和肺炎球菌等——青霉菌具有高强而广泛的杀菌作用被类似的实验证实了。

1928年9月15日,弗莱明在圣玛丽医学院公布了他的发现。他还于1929年2月13日向伦敦医学俱乐部提交了有关论文《青霉素——它的实际应用》,并被刊登在《新英格兰医学杂志》上。
神奇的黄色粉末
人类大规模地使用青霉素是什么时候?第二次世界大战的时候,那至少是 1939 年之后,也就是说从 1928 年发现这个东西到真正使用中间差着这几年呢。这十几年干什么了?
青霉素真正被运用于临床治疗是 20 世纪40年代的事了,这完全得益于牛津大学病理学家弗洛里(Howard Walter Florey, 1898~1968)和生物化学家钱恩(ErnstBoris Chain,1906~1979)的工作。
弗洛里 1898 年出生于澳大利亚,1921 年前往牛津大学读书,后在牛津大学担任病理学教授。他在 1938~1939 年对已知的由微生物产生的抗生物质进行了系统的研究。弗莱明发现的青霉素是最引起他注意的物质之一。
弗洛里花了大量的精力,招聘了一堆女孩儿给极低的工资,就靠这些女孩培养霉菌,当时牛津大学,你要是那个时候穿越回去看,没法看,所有能够装水的地方,甭管是一个烧杯还是浴缸全部在培养青霉菌,这些女孩被称之为青霉女孩,她们拼命试拼命试,至少证明一点青霉素是有效的,但是刚才我们讲的剂量问题仍然没有解决。
人类非常幸运,第二个巧遇和神秘时刻很快就到来了。有一天佛罗里手下一个研究员在水果市场上买水果,发现一只在角落里的哈密瓜长满了霉菌,就是已经发霉了,没法吃了,但是这个实验员一看这个哈密瓜上的霉菌骨骼清奇,望之不似池中之物长得很奇怪,于是马上跑到实验室。
一做实验发现,果然这种青霉的菌种可以把剂量提高两千多倍,这是一个多么幸运的时刻,当然不止这个人,当时美国人也参与进来,美国的那些大的制药公司也参与进来,就这样从一到两千多倍,到几万倍几十万倍,这样一点一点地提高。
1939年,他和德裔生物化学家钱恩决定对青霉菌培养物中的活性物质——青霉素进行提取和纯化,经过18个月的艰苦努力,他们终于得到了 100mg 纯度可满足人体肌肉注射的黄色粉末状的青霉素。
他们发现,加入100万倍溶剂配制成的青霉素溶剂,就可以阻止老鼠身上链球菌的生长。接着他们进行了人体实验,开始情况不错,但病人体内的细菌尚未完全消灭前,他们提炼的青霉素却已经用完了,虽然病人最终不治身亡,但青霉素的有效性却已得到了充分的证明。
1940年春天,他们又进行多次动物感染实验,结果都非常令人满意。于是同年8月,钱恩和弗洛里等人把对青霉素的重新研究的全部成果都刊登在著名的《柳叶刀》杂志上。
抗生素史上的重要里程碑
青霉素的发现标志着抗生素纪元即化学治疗的黄金时代的开始。青霉素大量应用以后,许多曾经严重危害人类的疾病,那些曾是不治之症的猩红热、化脓性咽喉炎、白喉、梅毒、淋病以及各种结核病、败血病、肺炎、伤寒等,都受到了有效的抑制。
青霉素奇迹般的疗效,开启了利用抗菌物质杀灭人体内致病菌的新思路。青霉素的发现促使科学家们在世界各地到处寻找新的抗菌物质。
1943年,俄国出生的生化学家瓦克斯曼博士发现另一种有效的抗生素——链霉素。这是一种由生长在土壤里的放线菌所产生的物质,它可以有效地治疗包括肺结核在内的一些疾病。此后的短短20余年内人们又陆续地发现了氯霉素、金霉素等数十种各有功效的抗生素。
抗生素的广泛应用,不仅充分地展示了它神奇的功效,同时,也尖锐地暴露出它的问题。在全世界应用青霉素总数超过亿剂后,出现了第一起由青霉素引发的死亡报告。后来,人们发现,多达 10%的人对青霉素有过敏反应,而且某些细菌也逐渐对青霉素产生耐药性。
尽管如此,青霉素的发现和成功应用仍然是划时代的成就,它为使用抗生素治疗传染病开辟了道路。为此,弗莱明、弗洛里和钱恩三人一起分享了1945年的诺贝尔生理学或医学奖。
(综编:科学网、科普中国、药理学、科学媒介中心)

